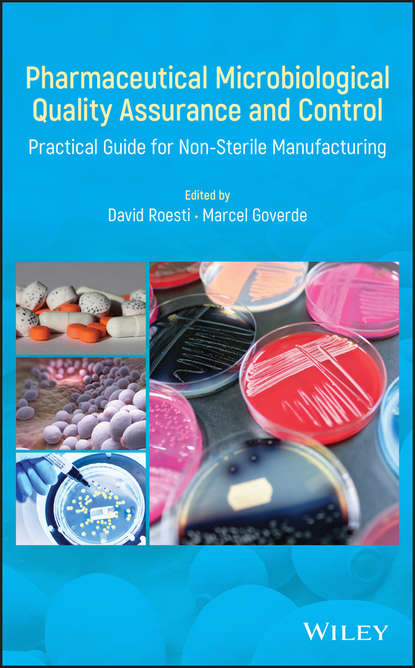
Pharmaceutical Microbiological Quality Assurance and Control

Pharmaceutical Microbiological Quality Assurance and Control
Relying on practical examples from the authors’ experience, this book provides a thorough and modern approach to controlling and monitoring microbial contaminations during the manufacturing of non-sterile pharmaceuticals. Offers a comprehensive guidance for non-sterile pharmaceuticals microbiological QA/QC Presents the latest developments in both regulatory expectations and technical advancements Provides guidance on statistical tools for risk assessment and trending of microbiological data Describes strategy and practical examples from the authors’ experience in globalized pharmaceutical companies and expert networks Offers a comprehensive guidance for non-sterile pharmaceuticals microbiological QA/QC Presents the latest developments in both regulatory expectations and technical advancements Provides guidance on statistical tools for risk assessment and trending of microbiological data Describes strategy and practical examples from the authors’ experience in globalized pharmaceutical companies and expert networks